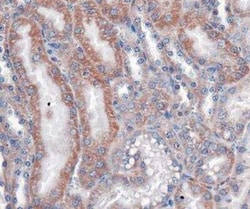
Invitrogen VLDLR Monoclonal Antibody (6A6) 100 &mu;L; Unconjugated:Antibodies,

missing translation for 'onlineSavingsMsg'
Learn More
Learn More
Invitrogen™ VLDLR Monoclonal Antibody (6A6)


Mouse Monoclonal Antibody
Brand: Invitrogen™ MA524790
This item is not returnable.
View return policy
Description
VLDLR Monoclonal Antibody for Western Blot, IHC (P), ICC/IF
The low density lipoprotein receptor (LDLR) gene family consists of cell surface proteins involved in receptor-mediated endocytosis of specific ligands. This gene encodes a lipoprotein receptor that is a member of the LDLR family and plays important roles in VLDL-triglyceride metabolism and the reelin signaling pathway. Mutations in this gene cause VLDLR-associated cerebellar hypoplasia. Alternative splicing generates multiple transcript variants encoding distinct isoforms for this gene.
Specifications
| VLDLR | |
| Monoclonal | |
| 1 mg/mL | |
| PBS with 0.02% sodium azide | |
| P98155, P98156, P98166 | |
| VLDLR | |
| Synthetic peptide corresponding to the C-terminus of human VLDL Receptor. | |
| 100 μL | |
| Primary | |
| Bovine, Human, Mouse, Rat | |
| Antibody | |
| IgG1 |
| Immunohistochemistry (Paraffin), Western Blot, Immunocytochemistry | |
| 6A6 | |
| Unconjugated | |
| VLDLR | |
| AA408956; AI451093; AW047288; CAMRQ1; CARMQ1; CHRMQ1; FLJ35024; non O-glycosylated VLDL-R; very low density lipoprotein receptor; very low density lipoprotein receptor VLDL-R2; very low-density lipoprotein receptor; VLDL receptor; VLDLR; VLDL-R; VLDLRCH | |
| Mouse | |
| Protein G | |
| RUO | |
| 22359, 25696, 282123, 7436 | |
| Store at 4°C short term. For long term storage, store at -20°C, avoiding freeze/thaw cycles. | |
| Liquid |
Product Content Correction
Your input is important to us. Please complete this form to provide feedback related to the content on this product.
Product Title
Spot an opportunity for improvement?Share a Content Correction